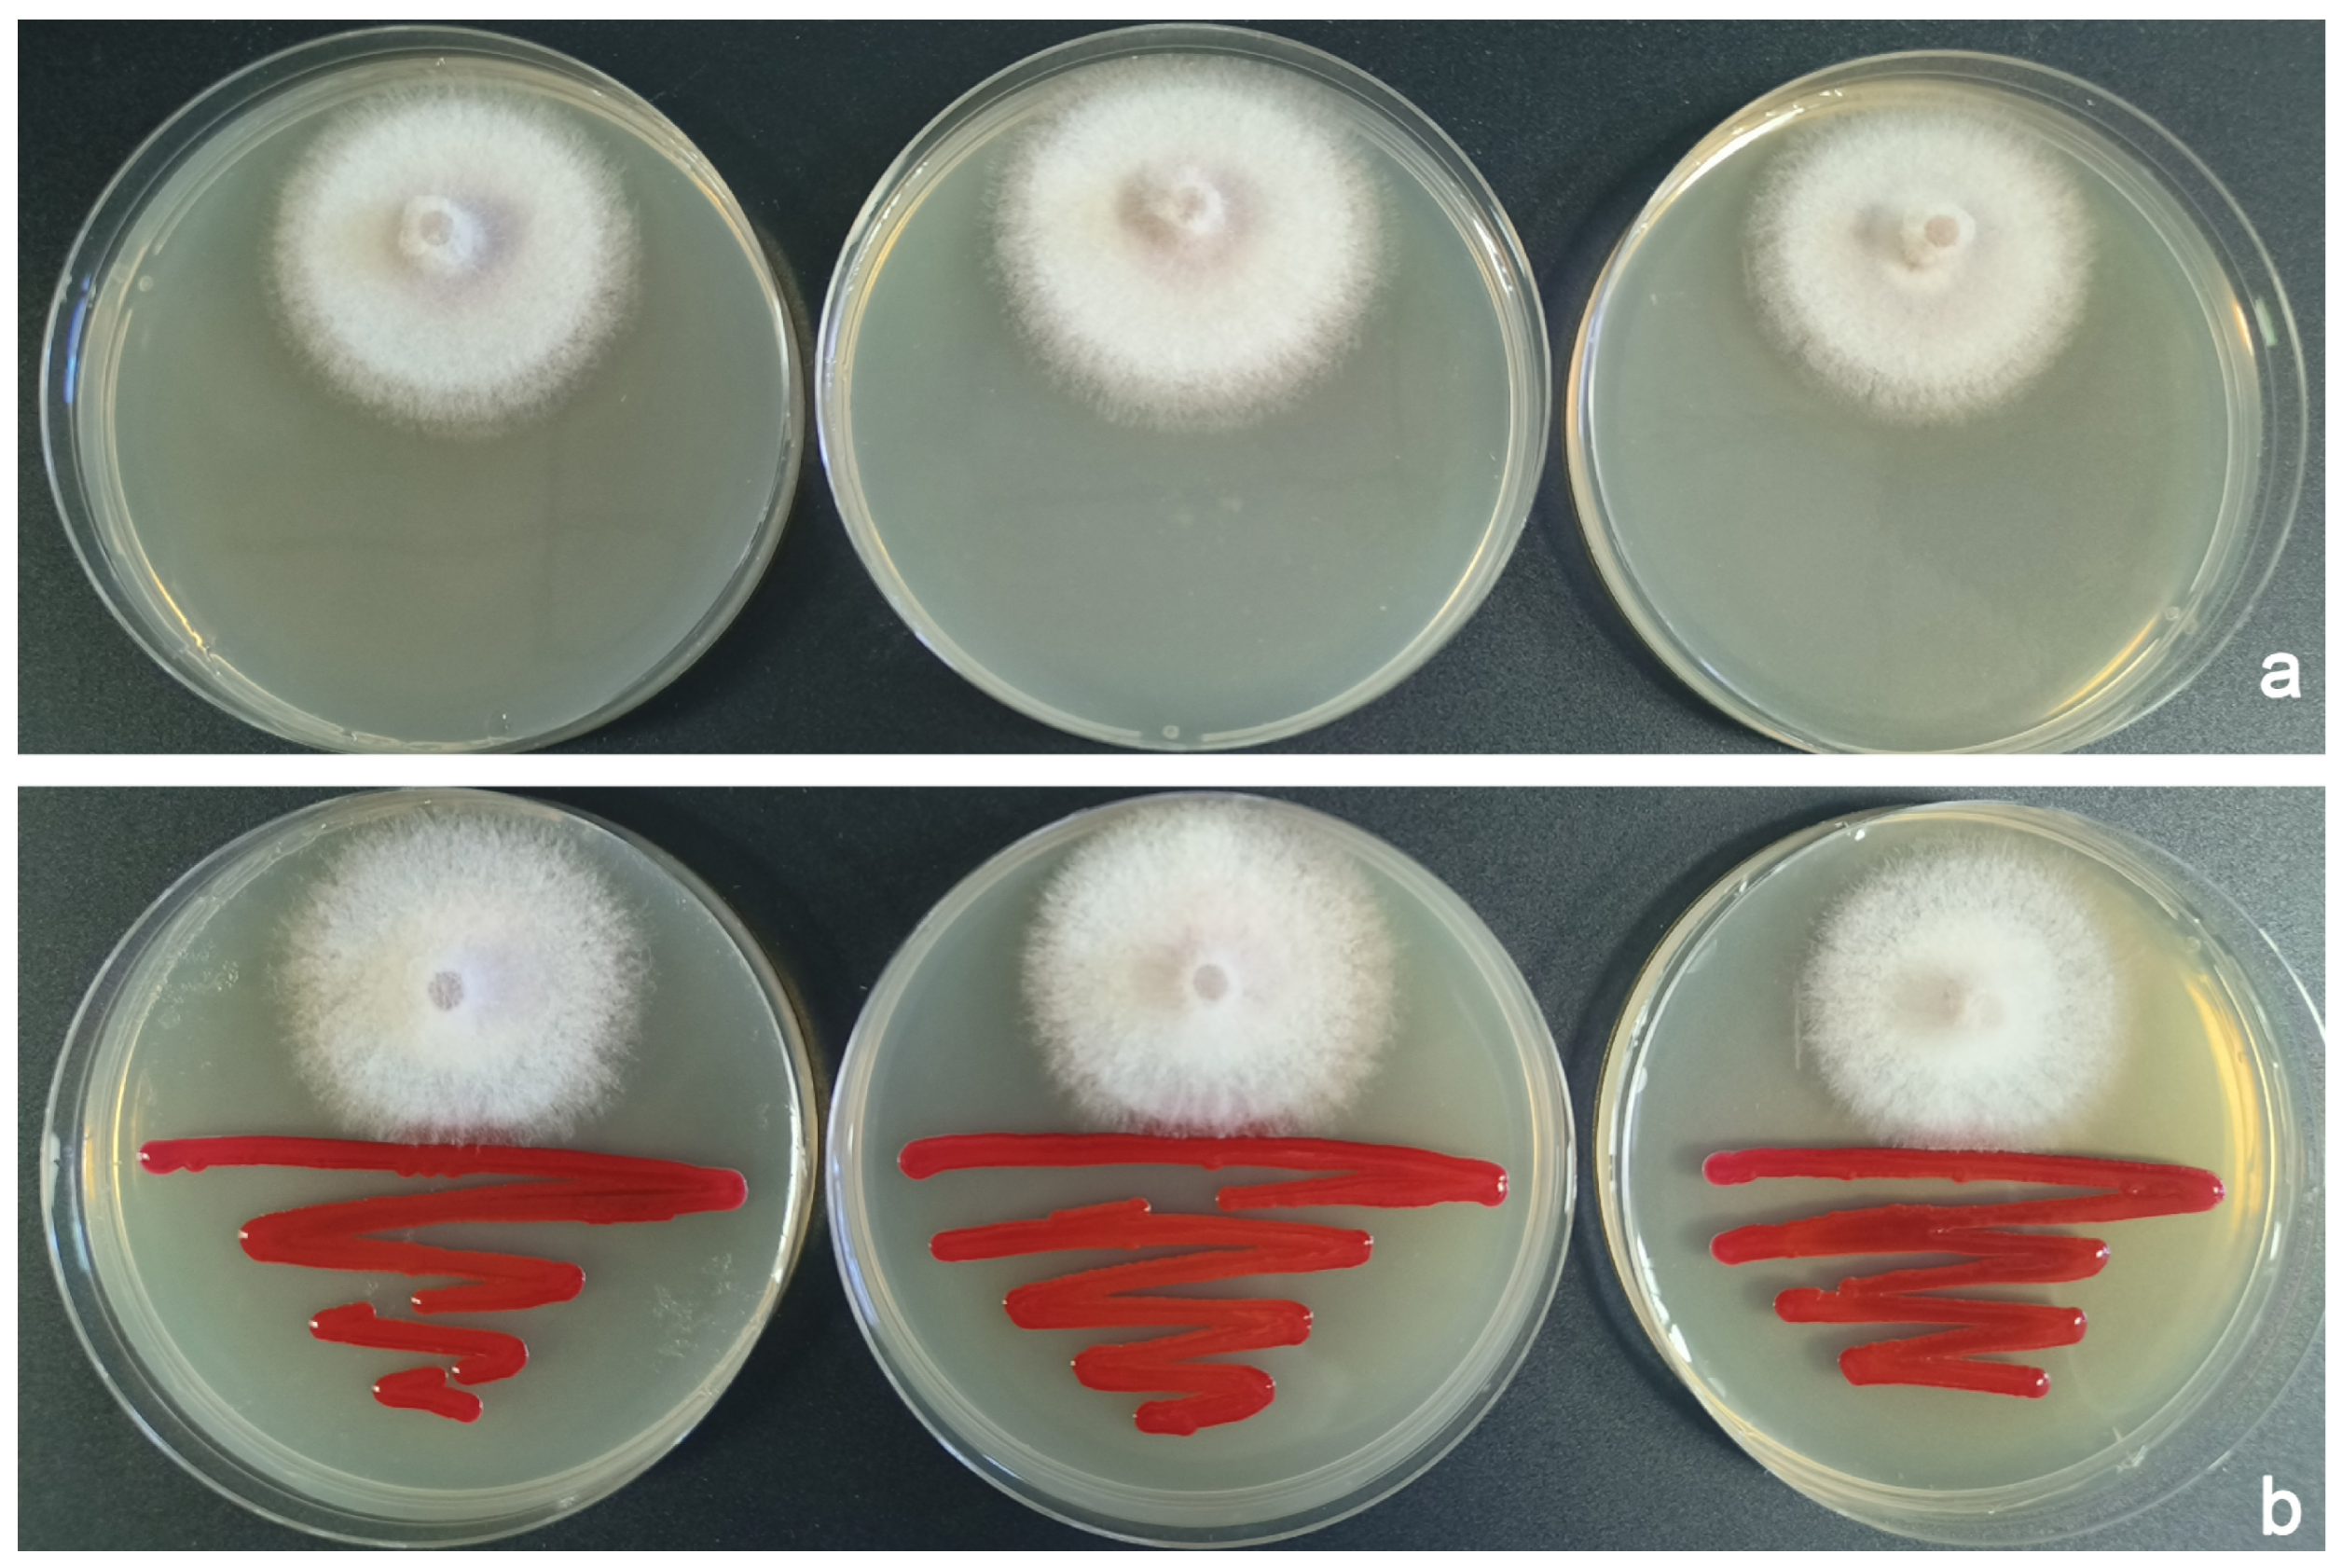
Insects 16 00056 g004

Laboratory Exploration of Several Potential Biocontrol Methods Against the Ambrosia Beetle, Euwallacea interjectus
Simple Summary
Abstract
1. Introduction
2. Materials and Methods
2.1. Beetle, Strain, and Mite Sources
2.2. Bioassays of B. bassiana and S. marcescens
2.2.1. Bioassay of B. bassiana Strain B-BB-1
- Petri dish experiments: B. bassiana conidia were suspended in sterile water with 0.1% Tween 80 to prepare concentrations of 105, 106, 107, and 108 viable spores/mL. The steps for the production of B. bassiana conidia are shown in the Supplementary Material Supporting text. Female E. interjectus adults were immersed in these suspensions or the control solution (Tween 80 alone) for 30 s, dried, and transferred to Petri dishes lined with moist sterile filter paper (10 beetles per dish, 6 replicates per concentration). The dishes were incubated at 25–28 °C, and survival was monitored daily. Dead beetles were incubated separately to confirm fungal infection. Mortality was corrected using Abbott’s formula [26].
- Artificial diet experiments: Treated beetles (106 to 108 viable spores/mL or control) were individually placed in 50 mL tubes containing 20 mL of artificial diet (30 replicates/treatment). The reason for treating the beetles with spores instead of the diet is that the high temperature during diet preparation could inactivate the spores. Additionally, the artificial diet is compacted in the tube with a paraffin-sealed surface, making it difficult for spores to penetrate and evenly distribute throughout the diet. After 20 days at 28 °C, the diet was dissected to evaluate parent beetle survival and offspring production. This approach was used as a preliminary model for Populus wood segments, as the artificial diet is easier to dissect for initial assessment.
- Poplar log experiments: Poplar logs were inoculated with female E. interjectus treated with spore powder or spore suspension, along with untreated controls (details in the Supplementary Material). Each log was inoculated with at least 30 beetles, with a minimum of 10 beetles per treatment, and the experiment was replicated across three logs (Figures S1a,b and S2). Every 2 days, the expelled sawdust was collected, dried, and weighed to assess beetle activity and survival. After 10 days, the logs were dissected to determine beetle survival rates and offspring production.
2.2.2. Bioassay of S. marcescens Strain B-SM-1
2.3. In Vitro Antagonism of F. populicola by B. bassiana and S. marcescens
2.4. Toxicity and Antifungal Effects of Prodigiosin Crude Extract (PCE)
2.5. Preference, Life Cycle, and Parasitism of Pyemotes Species on E. interjectus
2.6. Statistical Analysis
3. Results
3.1. Lethal Effect of B. bassiana and S. marcescens to E. interjectus
3.1.1. Lethal Effect of B. bassiana to E. interjectus
3.1.2. Lethal Effect of S. marcescens to E. interjectus
3.2. The Antagonistic Effects of B. bassiana and S. marcescens on F. populicola
3.2.1. B. bassiana Versus F. populicola
3.2.2. S. marcescens Versus F. populicola
3.3. Toxicity and Antifungal Effects of PCE
3.4. Preferences of the Two Pyemotes Species at Different Stages of E. interjectus Development
3.5. Life Cycles of the Two Pyemotes Species in the Parasitization of E. interjectus
3.6. Parasitism of Two Pyemotes Species on E. interjectus
4. Discussion
5. Conclusions
Supplementary Materials
Author Contributions
Funding
Data Availability Statement
Acknowledgments
Conflicts of Interest
References
- Lai, S.; Zhao, C.; Li, Y.; Zhou, Y.; Zhong, L.; Qiu, C.; Wang, H.; Pan, Y.; Dai, L.; Hao, D. Three novel Fusarium mutualists of ambrosia beetle Euwallacea interjectus in China. Mycol. Prog. 2022, 21, 70. [Google Scholar] [CrossRef]
- Hulcr, J.; Black, A.; Prior, K.; Chen, C.Y.; Li, H.F. Studies of ambrosia beetles (Coleoptera: Curculionidae) in their native ranges help predict invasion impact. Fla. Entomol. 2017, 100, 257–261. [Google Scholar] [CrossRef]
- Paap, T.; De Beer, Z.W.; Migliorini, D.; Nel, W.J.; Wingfield, M.J. The polyphagous shot hole borer (PSHB) and its fungal symbiont Fusarium euwallaceae: A new invasion in South Africa. Australas. Plant Pathol. 2018, 47, 231–237. [Google Scholar] [CrossRef]
- Mendel, Z.; Protasov, A.; Sharon, M.; Zveibil, A.; Yehuda, S.B.; O’Donnell, K.; Rabaglia, R.; Wysoki, M.; Freeman, S. Asian ambrosia beetle Euwallacea fornicatus and its novel symbiotic fungus Fusarium sp. pose a serious threat to the Israeli avocado industry. Phytoparasitica 2012, 40, 235–238. [Google Scholar] [CrossRef]
- Wang, L.; Chen, F.; Qiu, C.; Tang, J.; Ding, X.; Ren, J. Identification and risk analyses of Euwallacea interjectus. J. Nanjing For. Univ. 2021, 45, 201. [Google Scholar] [CrossRef]
- Landi, L.; Braccini, C.L.; Knížek, M.; Pereyra, V.A.; Marvaldi, A.E. A newly detected exotic ambrosia beetle in Argentina: Euwallacea interjectus (Coleoptera: Curculionidae: Scolytinae). Fla. Entomol. 2019, 102, 240–242. [Google Scholar] [CrossRef]
- Lv, J.; Lai, S.; Tian, S.; Zhou, Q.; Xiao, L.; He, P.; Wang, J. Taxonomic studies on the Xyleborini beetles from Jiangxi Province. J. Environ. Entomol. 2018, 40, 840–852, (In Chinese with English Abstract). [Google Scholar]
- Cognato, A.I.; Hoebeke, E.R.; Kajimura, H.; Smith, S.M. History of the exotic ambrosia beetles Euwallacea interjectus and Euwallacea validus (Coleoptera: Curculionidae: Xyleborini) in the United States. J. Econ. Entomol. 2015, 108, 1129–1135. [Google Scholar] [CrossRef] [PubMed]
- Kajii, C.; Morita, T.; Jikumaru, S.; Kajimura, H.; Yamaoka, Y.; Kuroda, K. Xylem dysfunction in ficus carica infected with wilt fungus Ceratocystis ficicola and the role of the vector beetle Euwallacea interjectus. IAWA J. 2013, 34, 301–312. [Google Scholar] [CrossRef]
- Wang, Z.; Li, Y.; Ernstsons, A.S.; Sun, R.; Hulcr, J.; Gao, L. The infestation and habitat of the ambrosia beetle Euwallacea interjectus (Coleoptera: Curculionidae: Scolytinae) in the riparian zone of Shanghai, China. Agric. For. Entomol. 2021, 23, 104–109. [Google Scholar] [CrossRef]
- Gugliuzzo, A.; Biedermann, P.H.; Carrillo, D.; Castrillo, L.A.; Egonyu, J.P.; Gallego, D.; Haddi, K.; Hulcr, J.; Jactel, H.E.; Kajimura, H.; et al. Recent advances toward the sustainable management of invasive Xylosandrus ambrosia beetles. J. Pest Sci. 2021, 94, 615–637. [Google Scholar] [CrossRef]
- Mukasa, Y.; Kyamanywa, S.; Sserumaga, J.P.; Otim, M.; Tumuhaise, V.; Erbaugh, M.; Egonyu, J.P. An atoxigenic L-strain of Aspergillus flavus (Eurotiales: Trichocomaceae) is pathogenic to the coffee twig borer, Xylosandrus compactus (Coleoptera: Curculionidea: Scolytinae). Environ. Microbiol. Rep. 2019, 11, 508–517. [Google Scholar] [CrossRef]
- Kushiyev, R.; Tuncer, C.; Erper, I.; Ozdemir, I.O.; Saruhan, I. Efficacy of native entomopathogenic fungus, Isaria fumosorosea, against bark and ambrosia beetles, Anisandrus dispar Fabricius and Xylosandrus germanus Blandford (Coleoptera: Curculionidae: Scolytinae). Egypt. J. Biol. Pest Control 2018, 28, 1–6. [Google Scholar] [CrossRef]
- Sundararajan, P.; Rajaselvi, D.D.; Vivekananthan, S.; Ramasamy, S.P. In-silico method for elucidation of prodigiosin as PARP-1 inhibitor a prime target of Triple-negative breast cancer. Bioorg. Chem. 2023, 138, 106618. [Google Scholar] [CrossRef]
- Pineda-Castellanos, M.L.; Rodríguez-Segura, Z.; Villalobos, F.J.; Hernández, L.; Lina, L.; Nuñez-Valdez, M.E. Pathogenicity of isolates of Serratia marcescens towards larvae of the scarab Phyllophaga blanchardi (Coleoptera). Pathogens 2015, 4, 210–228. [Google Scholar] [CrossRef] [PubMed]
- Gugliuzzo, A.; Aiello, D.; Biondi, A.; Giurdanella, G.; Siscaro, G.; Zappal, A.L.; Vitale, A.; Garzia, G.T.; Polizzi, G. Microbial mutualism suppression by Trichoderma and Bacillus species for controlling the invasive ambrosia beetle Xylosandrus compactus. Biol. Control 2022, 170, 104929. [Google Scholar] [CrossRef]
- Jones, M.E.; Paine, T.D. Potential pesticides for control of a recently introduced ambrosia beetle (Euwallacea sp.) in southern California. J. Pest Sci. 2018, 91, 237–246. [Google Scholar] [CrossRef]
- Akşit, T.; Cakmak, I.; Moser, J. Attack by Pyemotes johnmoseri (Acari: Pyemotidae) on Hypoborus ficus (Coleoptera: Scolytidae) in fig trees in Turkey. Exp. Appl. Acarol. 2007, 41, 251–254. [Google Scholar] [CrossRef] [PubMed]
- Yu, L.; Liang, L. A new species of Pyemotes (Acari: Pyemotidae) parasitic on bark beetles (Coleoptera: Scolytidae) from Hebei, China. Syst. Appl. Acarol. 1996, 1, 167–171. [Google Scholar] [CrossRef]
- Moser, J.C.; Kiełczewski, B.; Wiśniewski, J.; Bałazy, S. Evaluating Pyemotes dryas (Vitzthum 1923) (Acari: Pyemotidae) as a parasite of the southern pine beetle. Int. J. Acarol. 1978, 4, 67–70. [Google Scholar] [CrossRef]
- Yu, L.; Zhang, Z.; He, L. Two new species of Pyemotes closely related to P. tritici (Acari: Pyemotidae). Zootaxa 2010, 2723, 1–40. [Google Scholar] [CrossRef]
- Weiser, J.; Sláma, K. Effects of the toxin of Pyemotes (Acarina: Pyemotidae) on the insect prey, with special reference to respiration. Ann. Entomol. Soc. Am. 1964, 57, 479–482. [Google Scholar] [CrossRef]
- Tang, H.; Zheng, J.; Wang, D. An effective method for biological control of Anoplophora glabripennis (Coleoptera: Cerambycidae) by using a vector mite, Pyemotes moseri (Acarina: Pyemotidae), carrying insecticidal fungi. Sci. Silvae Sin. 2022, 58, 157–164, (In Chinese with English Abstract). [Google Scholar]
- Liu, X.; Nie, Z.; Chi, D.; He, L. Toxicity and killing effect of Beauveria bassiana and Pyemotes zhonghuajia on Dioryctria abietella and related enzyme activities. J. Northeast For. Univ. 2023, 51, 139–146. [Google Scholar] [CrossRef]
- Zheng, L.; Lai, S.; Zhou, Y.; Jiang, N.; Hao, D.; Dai, L. Biology of Euwallacea interjectus, an emerging poplar pest, reared on an ambrosia beetle artificial diet and medium of fungal symbiont. Bull. Entomol. Res. 2024, 114, 405–415. [Google Scholar] [CrossRef] [PubMed]
- Abbott, W.S. A method of computing the effectiveness of an insecticide. J. Econ. Entomol. 1925, 18, 265–267. [Google Scholar] [CrossRef]
- Panebianco, S.; Vitale, A.; Polizzi, G.; Scala, F.; Cirvilleri, G. Enhanced control of postharvest citrus fruit decay by means of the combined use of compatible biocontrol agents. Biol. Control 2015, 84, 19–27. [Google Scholar] [CrossRef]
- Fernandez, K.X.; Pokorny, S.; Ishangulyeva, G.; Ullah, A.; Todorova, S.I.; Erbilgin, N.; Carroll, A.L.; Vederas, J.C. Beauveria bassiana exhibits strong virulence against Dendroctonus ponderosae in greenhouse and field experiments. Appl. Microbiol. Biotechnol. 2023, 107, 3341–3352. [Google Scholar] [CrossRef] [PubMed]
- Castrejón-Antonio, J.E.; Tamez-Guerra, P.; Montesinos-Matías, R.; Ek-Ramos, M.J.; Garza-López, P.M.; Arredondo-Bernal, H.C. Selection of Beauveria bassiana (Hypocreales: Cordycipitaceae) strains to control Xyleborus affinis (Curculionidae: Scolytinae) females. PeerJ 2020, 8, e9472. [Google Scholar] [CrossRef]
- Castrillo, L.A.; Griggs, M.H.; Ranger, C.M.; Reding, M.E.; Vandenberg, J.D. Virulence of commercial strains of Beauveria bassiana and Metarhizium brunneum (Ascomycota: Hypocreales) against adult Xylosandrus germanus (Coleoptera: Curculionidae) and impact on brood. Biol. Control 2011, 58, 121–126. [Google Scholar] [CrossRef]
- Castrejón-Antonio, J.E.; Tamez-Guerra, P.; García-Ortiz, N.; Muñiz-Paredes, F.; Sánchez-Rangel, J.C.; Montesinos-Matías, R. Biocontrol of Xyleborus affinis (Curculionidae: Scolitinae) females and progeny by Beauveria bassiana (Hypocreales: Cordycipitaceae) in a sawdust artificial diet model. Insects 2023, 14, 477. [Google Scholar] [CrossRef] [PubMed]
- Castrillo, L.A.; Griggs, M.H.; Vandenberg, J.D. Granulate ambrosia beetle, Xylosandrus crassiusculus (Coleoptera: Curculionidae), survival and brood production following exposure to entomopathogenic and mycoparasitic fungi. Biol. Control 2013, 67, 220–226. [Google Scholar] [CrossRef]
- Prabhukarthikeyan, R.; Saravanakumar, D.; Raguchander, T. Combination of endophytic Bacillus and Beauveria for the management of Fusarium wilt and fruit borer in tomato. Pest Manag. Sci. 2014, 70, 1742–1750. [Google Scholar] [CrossRef] [PubMed]
- Zhang, P.; Zhao, Q.; Ma, X.; Ma, L. Pathogenicity of Serratia marcescens to hazelnut weevil (Curculio dieckmanni). J. For. Res. 2021, 32, 409–417. [Google Scholar] [CrossRef]
- Wang, M.; Chen, H.; Xie, D.; Xiang, J.; Yu, J.; Chi, D. Composition and structure of culturable bacterial community in the intestinal of Hylurgus ligniperda Fabricius. J. Northeast For. Univ. 2024, 52, 109–114. [Google Scholar] [CrossRef]
- Qi, H.; Wang, J.; Endoh, R.; Takeuchi, Y.; Tarno, H.; Futai, K. Pathogenicity of microorganisms isolated from the oak platypodid, Platypus quercivorus (Murayama) (Coleoptera: Platypodidae). Appl. Entomol. Zool. 2011, 46, 201–210. [Google Scholar] [CrossRef]
- Moore, G.E. Pathogenicity of ten strains of bacteria to larvae of the southern pine beetle. J. Invertebr. Pathol. 1972, 20, 41–45. [Google Scholar] [CrossRef]
- Guo, Z.; Zhang, X.; Wu, J.; Yu, J.; Xu, M.; Chen, D.; Zhang, Z.; Li, X.; Chi, Y.; Wan, S. In vitro inhibitory effect of the bacterium Serratia marcescens on Fusarium proliferatum growth and fumonisins production. Biol. Control 2020, 143, 104188. [Google Scholar] [CrossRef]
- Suryawanshi, R.K.; Patil, C.D.; Borase, H.P.; Narkhede, C.P.; Salunke, B.K.; Patil, S.V. Mosquito larvicidal and pupaecidal potential of prodigiosin from Serratia marcescens and understanding its mechanism of action. Pestic. Biochem. Physiol. 2015, 123, 49–55. [Google Scholar] [CrossRef] [PubMed]
- Hu, W.; Zheng, R.; Liao, Y.; Kuang, F.; Yang, Z.; Chen, T.; Zhang, N. Evaluating the biological potential of prodigiosin from Serratia marcescens KH-001 against Asian citrus psyllid. J. Econ. Entomol. 2021, 114, 1219–1225. [Google Scholar] [CrossRef] [PubMed]
- Alijani, Z.; Amini, J.; Ashengroph, M.; Bahramnejad, B. Antifungal activity of Serratia rubidaea Mar61-01 purified prodigiosin against Colletotrichum nymphaeae, the causal agent of strawberry anthracnose. J. Plant Growth Regul. 2022, 41, 585–595. [Google Scholar] [CrossRef]
- Jimtha, C.J.; Jishma, P.; Sreelekha, S.; Chithra, S.; Radhakrishnan, E.K. Antifungal properties of prodigiosin producing rhizospheric Serratia sp. Rhizosphere 2017, 3, 105–108. [Google Scholar] [CrossRef]
- Gutiérrez-Román, M.I.; Holguín-Meléndez, F.; Bello-Mendoza, R.; Guillén-Navarro, K.; Dunn, M.F.; Huerta-Palacios, G. Production of prodigiosin and chitinases by tropical Serratia marcescens strains with potential to control plant pathogens. World J. Microbiol. Biotechnol. 2012, 28, 145–153. [Google Scholar] [CrossRef] [PubMed]
- Mann, A.J.; Davis, T.S. Entomopathogenic fungi to control bark beetles: A review of ecological recommendations. Pest Manag. Sci. 2021, 77, 3841–3846. [Google Scholar] [CrossRef] [PubMed]
- Kaiser, D.; Bacher, S.; Mène Saffrané, L.; Grabenweger, G. Efficiency of natural substances to protect Beauveria bassiana conidia from UV radiation. Pest Manag. Sci. 2019, 75, 556–563. [Google Scholar] [CrossRef]
- Liu, J.; He, X.; Ye, S.; Zhou, J.; Han, P.; Gao, Y.; Yang, M. Pest management of postharvest potatoes: Lethal, sublethal and transgenerational effects of the ectoparasitic mite Pyemotes zhonghuajia on the potato worm Phthorimaea operculella. Pest Manag. Sci. 2023, 79, 5250–5259. [Google Scholar] [CrossRef] [PubMed]

| Treatment | Survival (Mean ± SE%) | Offspring Production (Mean ± SE%) |
|---|---|---|
| 108 | 0.00 ± 0.00 c | 3.33 ± 3.28 d |
| 107 | 0.00 ± 0.00 c | 23.33 ± 7.72 bc |
| 106 | 36.67 ± 8.80 b | 43.33 ± 9.05 b |
| Control | 83.33 ± 6.80 a | 70.00 ± 8.37 a |
| Treatment | The Relative Quantity of the Opisthosoma | |||
|---|---|---|---|---|
| (Mean ± SE%) | ||||
| Adults | Pupae | Larvae | ||
| P. moseri | 1.45 ± 0.71 b | 74.84 ± 7.46 a | 23.71 ± 7.85 ab | H = 10.898, df = 2, p = 0.004 |
| P. zhonghuajia | 2.77 ± 1.17 b | 78.05 ± 5.35 a | 19.17 ± 5.58 ab | H = 10.674, df = 2, p = 0.005 |
| t = −0.866, df = 8, p = 0.412 | t = −0.313, df = 8, p = 0.762 | t = 0.421, df = 8, p = 0.685 | ||
| Treatment | Number of Opisthosomata (Mean ± SE) | Total Number of Offspring (Mean ± SE) | Number of Offspring per Opisthosoma (Mean ± SE) |
|---|---|---|---|
| P. moseri | 50.10 ± 2.23 | 549.10 ± 76.89 | 10.96 ± 1.58 |
| P. zhonghuajia | 52.70 ± 3.57 | 707.00 ± 97.60 | 13.42 ± 2.68 |
| t = −0.585, df = 18, p = 0.566 | t = −1.206, df = 18, p = 0.244 | t = −1.094, df = 18, p = 0.288 |
Disclaimer/Publisher’s Note: The statements, opinions and data contained in all publications are solely those of the individual author(s) and contributor(s) and not of MDPI and/or the editor(s). MDPI and/or the editor(s) disclaim responsibility for any injury to people or property resulting from any ideas, methods, instructions or products referred to in the content. |
© 2025 by the authors. Licensee MDPI, Basel, Switzerland. This article is an open access article distributed under the terms and conditions of the Creative Commons Attribution (CC BY) license (https://creativecommons.org/licenses/by/4.0/).
Share and Cite
Liu, J.; Jiang, N.; Gao, H.; Lai, S.; Zhou, Y.; Hao, D.; Dai, L. Laboratory Exploration of Several Potential Biocontrol Methods Against the Ambrosia Beetle, Euwallacea interjectus. Insects 2025, 16, 56. https://doi.org/10.3390/insects16010056
Liu J, Jiang N, Gao H, Lai S, Zhou Y, Hao D, Dai L. Laboratory Exploration of Several Potential Biocontrol Methods Against the Ambrosia Beetle, Euwallacea interjectus. Insects. 2025; 16(1):56. https://doi.org/10.3390/insects16010056
Chicago/Turabian StyleLiu, Jialin, Nan Jiang, Haiming Gao, Shengchang Lai, Yang Zhou, Dejun Hao, and Lulu Dai. 2025. "Laboratory Exploration of Several Potential Biocontrol Methods Against the Ambrosia Beetle, Euwallacea interjectus" Insects 16, no. 1: 56. https://doi.org/10.3390/insects16010056
APA StyleLiu, J., Jiang, N., Gao, H., Lai, S., Zhou, Y., Hao, D., & Dai, L. (2025). Laboratory Exploration of Several Potential Biocontrol Methods Against the Ambrosia Beetle, Euwallacea interjectus. Insects, 16(1), 56. https://doi.org/10.3390/insects16010056





